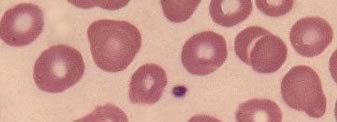
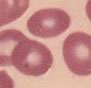
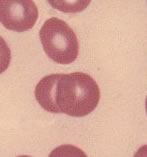
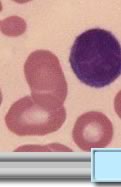

|
 |
 |
| MICROCITO (MICROCITOSIS) |
|
Hematíes maduros de un diámetro inferior a 6.5 micras y un volumen corpuscular de <80 fl. Usualmente normocrómicos pero pueden ser hipocrómicos y muestran una palidez en el centro. En condiciones normales son < 10% de los eritrocitos Se presentan en las siguientes condiciones: - Anemia ferropénica |
||||||||||||||||||||||||||||||||||||||||||||||||||||||||||||||||||||||||||||||||||||||||||||||
| Página revisada el 14 de Marzo de 2009. Equipo de redacción de IQB | |||||||||||||||||||||||||||||||||||||||||||||||||||||||||||||||||||||||||||||||||||||||||||||||